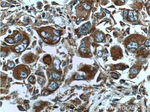
ATP6 Antibody in Immunohistochemistry (Paraffin) (IHC (P))
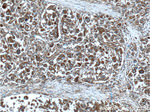
ATP6 Antibody in Immunohistochemistry (Paraffin) (IHC (P))

Search
Proteintech
ATP6 Polyclonal Antibody
{{$productOrderCtrl.translations['antibody.pdp.commerceCard.promotion.promotions']}}
{{$productOrderCtrl.translations['antibody.pdp.commerceCard.promotion.viewpromo']}}
{{$productOrderCtrl.translations['antibody.pdp.commerceCard.promotion.promocode']}}: {{promo.promoCode}} {{promo.promoTitle}} {{promo.promoDescription}}. {{$productOrderCtrl.translations['antibody.pdp.commerceCard.promotion.learnmore']}}
产品信息
55313-1-AP
已发表种属
宿主/亚型
分类
类型
抗原
偶联物
形式
浓度
规格
保存条件
运输条件
靶标信息
The MT-ATP6 gene provides information for making a protein that is essential for normal mitochondrial function. Mitochondria are structures within cells that convert the energy from food into a form that cells can use. These cellular structures produce energy through a process called oxidative phosphorylation, which uses oxygen and simple sugars to create adenosine triphosphate (ATP), the cell's main energy source. The MT-ATP6 protein forms one part (subunit) of a large enzyme called ATP synthase. This enzyme, which is also known as complex V, is responsible for the final step of oxidative phosphorylation. Specifically, one segment of ATP synthase allows positively charged particles, called protons, to flow across a specialized membrane inside mitochondria. Another segment of the enzyme uses the energy created by this proton flow to convert a molecule called adenosine diphosphate (ADP) to ATP.
仅用于科研。不用于诊断过程。未经明确授权不得转售。